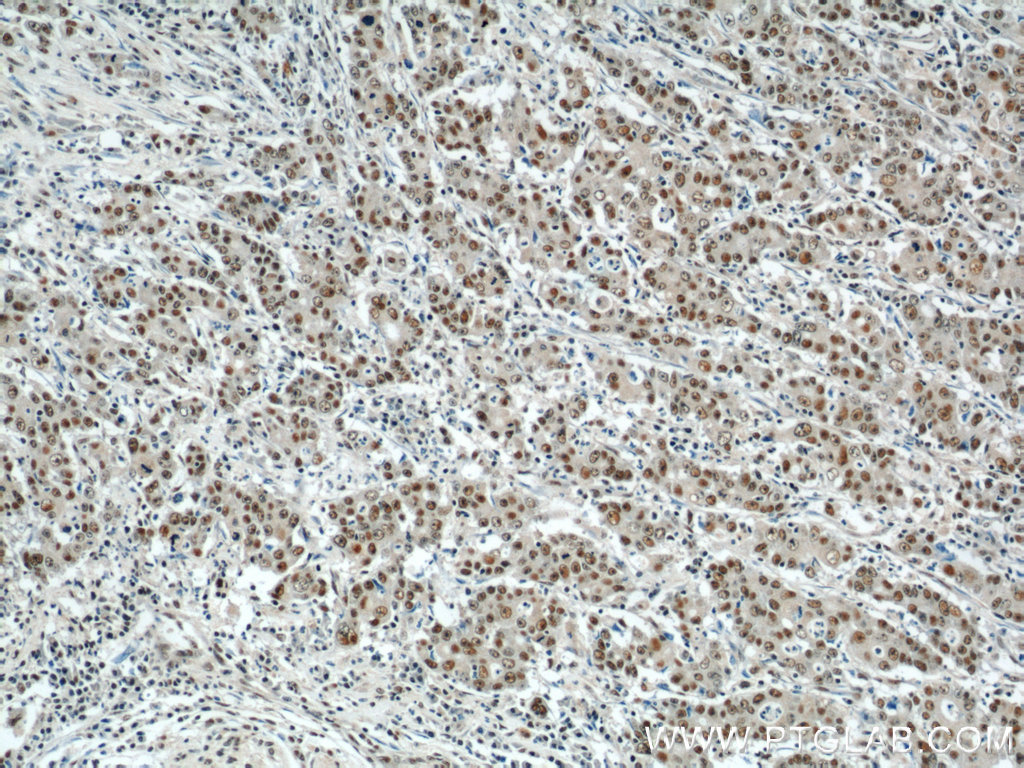

CDK8抗体
产品名称: CDK8抗体
英文名称: CDK8Antibody
产品编号: XY22067-1
产品价格: null
产品产地: 中国/美国
品牌商标: XYbscience
更新时间: 2023-08-17T09:55:27
使用范围: WB,ELISA,IHC-P,IHC-F,IF
- 联系人 : 徐经理
- 地址 : 上海市闵行莘庄工业区春东路508号A1-2F
- 邮编 : 200612
- 所在区域 : 上海
- 电话 : 152****8802 点击查看
- 传真 : 点击查看
- 邮箱 : shxysw02@163.com
- 二维码 : 点击查看
CDK8抗体
IP = Immunoprecipitation
XY060Ca21 白介素13(IL13)单克隆抗体 Monoclonal Antibody to Interleukin 13 (IL13) Canis familiaris; Canine (Dog)
XY060Eq21 白介素13(IL13)单克隆抗体 Monoclonal Antibody to Interleukin 13 (IL13) Equus caballus; Equine (Horse)
XY060Ga21 白介素13(IL13)单克隆抗体 Monoclonal Antibody to Interleukin 13 (IL13) Chicken (Gallus)
XY060Po21 白介素13(IL13)单克隆抗体 Monoclonal Antibody to Interleukin 13 (IL13) Sus scrofa; Porcine (Pig)
XY060Ra21 白介素13(IL13)单克隆抗体 Monoclonal Antibody to Interleukin 13 (IL13) Rattus norvegicus (Rat)
XY061Bo21 白介素15(IL15)单克隆抗体 Monoclonal Antibody to Interleukin 15 (IL15) Bos taurus; Bovine (Cattle)
XY061Ra21 白介素15(IL15)单克隆抗体 Monoclonal Antibody to Interleukin 15 (IL15) Rattus norvegicus (Rat)
XY062Bo21 白介素16(IL16)单克隆抗体 Monoclonal Antibody to Interleukin 16 (IL16) Bos taurus; Bovine (Cattle)
XY062Ga21 白介素16(IL16)单克隆抗体 Monoclonal Antibody to Interleukin 16 (IL16) Chicken (Gallus)
XY063Bo21 白介素17(IL17)单克隆抗体 Monoclonal Antibody to Interleukin 17 (IL17) Bos taurus; Bovine (Cattle)
XY063Ca21 白介素17(IL17)单克隆抗体 Monoclonal Antibody to Interleukin 17 (IL17) Canis familiaris; Canine (Dog)
XY063Eq21 白介素17(IL17)单克隆抗体 Monoclonal Antibody to Interleukin 17 (IL17) Equus caballus; Equine (Horse)
XY063Ga21 白介素17(IL17)单克隆抗体 Monoclonal Antibody to Interleukin 17 (IL17) Chicken (Gallus)
XY063Po21 白介素17(IL17)单克隆抗体 Monoclonal Antibody to Interleukin 17 (IL17) Sus scrofa; Porcine (Pig)